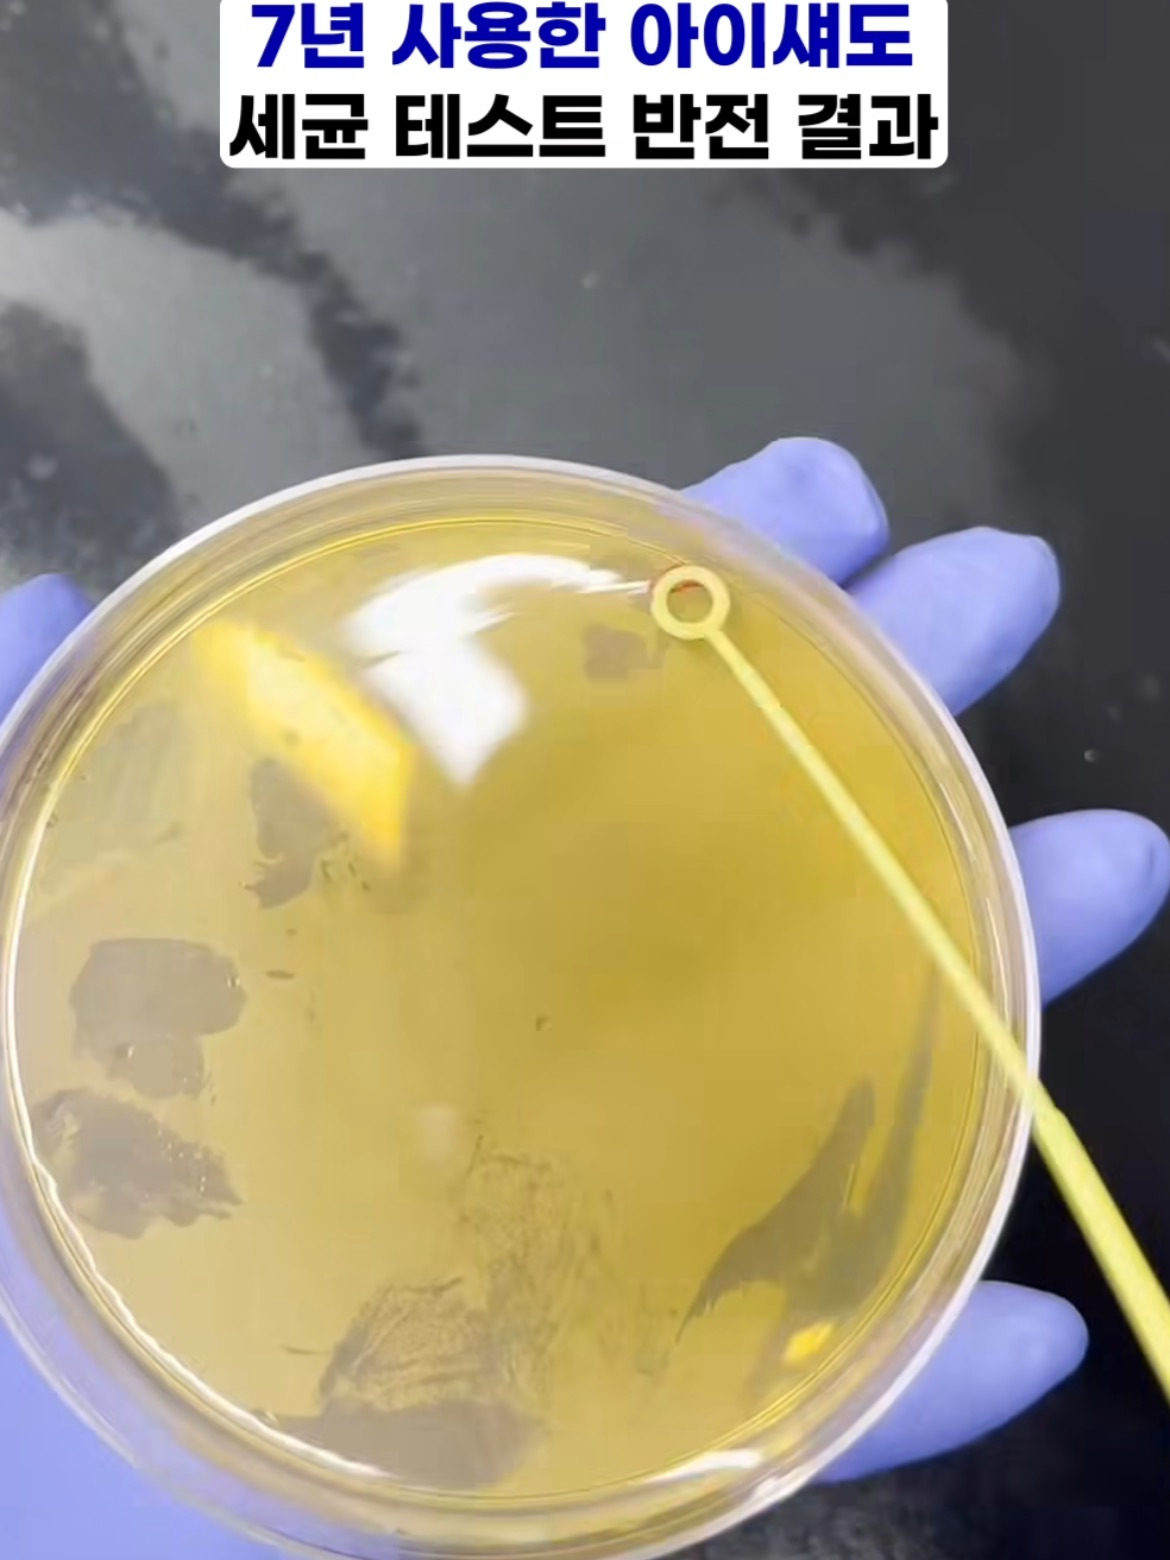
회사원a-가루네버다이-실험-아는-사람?-2-이미지

출처: https://youtu.be/NdyKCZ7ZfBw?si=ZAbpM4s5608L8biy

립스틱 실험 결과도 나옴






기초, 파데, 틴트는 액체니까 당연 해당 안 됨
립스틱이라고 무조건 안 상하는 건 아닐 테니
사용 직후 피부 상태나 냄새 이상하면 버리기
가루여도 막 오십 년 넘은 이런 건 쓰면 안 됨
상한 게 문제가 아니라 납 때문에
출처: https://youtu.be/NdyKCZ7ZfBw?si=ZAbpM4s5608L8biy

립스틱 실험 결과도 나옴

기초, 파데, 틴트는 액체니까 당연 해당 안 됨
립스틱이라고 무조건 안 상하는 건 아닐 테니
사용 직후 피부 상태나 냄새 이상하면 버리기
가루여도 막 오십 년 넘은 이런 건 쓰면 안 됨
상한 게 문제가 아니라 납 때문에